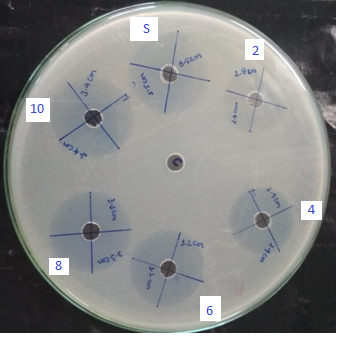

1A. U. College of Pharmaceutical Sciences, Andhra University, Visakhapatnam 530003, A. P, India, 2Department of Inorganic and Analytical Chemistry, Andhra University, Visakhapatnam 530003, A. P, India
*Email: ramajoy90@gmail.com
Received: 18 Sep 2021, Revised and Accepted: 02 Feb 2022
ABSTRACT
Objective: In the present study, we have discussed the antibacterial activity of methanolic extract of Grewia tiliaefolia Vahl leaf and the isolation of pure phytochemicals by using column chromatography.
Methods: The powdered material was extracted with methanol using a soxhlet extractor and isolation of compounds by column chromatography. Evaluation of antibacterial activity determined the zone of inhibition by disc diffusion method.
Results: Three compounds were isolated from methanolic extract of the leaf of Grewia tiliaefolia using column chromatography, namely daucosterol, lupeol, and friedelin were purified after isolation and characterized by using UV, FTIR, NMR, MASS spectroscopic techniques, and antimicrobial activity was carried out on the crude methanolic extract a higher zone of inhibition was observed against Staphylococcus aureus with a zone diameter of 34.1±0.513 mm at a concentration of 10 mg/ml.
Conclusion: The results observed in this research work conclude that the methanolic extract showed good antibacterial activity may be due to the compounds isolated like daucosterol, lupeol, and friedelin.
Keywords: Grewia tiliaefolia, Antibacterial activity, Lupeol, Friedelin, Daucosterol, Column chromatography
© 2022 The Authors. Published by Innovare Academic Sciences Pvt Ltd. This is an open access article under the CC BY license (https://creativecommons.org/licenses/by/4.0/)
DOI: https://dx.doi.org/10.22159/ijpps.2022v14i4.44105. Journal homepage: https://innovareacademics.in/journals/index.php/ijpps.
Plant products, either as pure compounds or as homogenous plant extracts are getting popularity and extraordinary importance because of vast opportunities for new drug discoveries [1]. Grewia tiliaefolia Vahl belongs to the family Tiliaceae. There are around 50 genera and 450 species in the family, Tiliaceae. Many plant species of genus Grewia were known for their medicinal properties to treat several diseases. Ayurveda refers to the utilization of various plant portions of the variety Grewia to fix aggravation, consuming sensation, fever, blood issues, wound mending, ulcerative colitis, heavy menstrual flow, and diabetes [2-4]. Triterpenoids, steroids, glycosides, flavones, lignans, phenolics, alkaloids, lactones, anthocyanins, flavones, and organic acids have been isolated from various species of this genus. The extracts and preparations from the various plants, which are expectantly safe, exhibited various biological effects, e. g. anti-oxidant, antibacterial, hepatoprotective, anti-inflammatory, anti-emetic, anti-malarial, and analgesic. Phytochemicals present in natural products have been proved to cure many complicated diseases so the researchers have always focused on the isolation of bioactive molecules from medicinally important herbs and trees. Many pharmaceutical companies are focusing on the scope for incorporating new drugs in the market [5-9].
In the present investigation, the methanolic extract was tested for antibacterial activity and due to the presence of phytoconstituents, it is subjected to column chromatography for isolation and characterization of compounds isolated from high polar methanolic extract of Grewia tiliaefolia Vahl leaf.
Instruments
Rotavap (Buchi Labortechnik AG, CH-929 Flawil 1, Switzerland), Vacuum Pump (Millipore) Vacuum PR, Pump 4 BAR, UV-Visible Spectrophotometer (Thermo Scientific UV-10), Fluorescent UV, all melting points were determined in the OptiMelt automated melting point apparatus, UV spectra were taken on systemic UV visible spectrophotometer, IR spectra were recorded in KBR pellet on JASCO FT/IR interferometer, Mass spectra were recorded with Shimadzu LCMS-2010 series instrument. 1H NMR and 13C NMR were recorded with Bruker 300 and 400 MHz instruments in 1H NMR and 13C NMR spectra the chemical shifts are given in δ ppm.
Source of chemicals and drugs
Glass column, test tubes, boiling tubes, conical flasks, beakers, TLC plates, TLC chambers, capillaries, different reagents for preliminary screening, solvents like hexane, ethyl acetate, methanol. All chemicals and solvents were of the analytical grade obtained from SD Fine Chemical Pvt. Ltd., Mumbai, Sigma Chemical Company, U. S. A., and Loba Chemic, Mumbai, India. Silica gel G for TLC-Merk India, Silica gel G for Column Chromatography (60-120 mesh size)-Merk India, Glass column, TLC plates (10x2 cm, 20x5 cm), Chemical reagents (AR grade) were purchased from Merk Chemicals, Mumbai; Sigma Chemical Co., St. Louis, U. S. A.
Source of micro-organisms
Staphylococcus aureaus NCIM-2079, Escherichia coli NCIM-2065, Pseudomonas aeruginosa NCIM-2037, Bacillus subtilis NCIM-2063. Cultures were obtained from the national collection of industrial microorganisms (NCIM) which were available as a stock culture in the pharmaceutical biotechnology division, Andhra University, Visakhapatnam.
Collection and preparation of plant extract
The plant material was collected from the Kambala Konda forest area of Visakhapatnam, Andhra Pradesh, and authenticated by Dr. S. B. Padal, taxonomist, Department of Botany, Andhra University, Visakhapatnam with the voucher specimen number A. U. (B. D. H), No.22231 was deposited in the herbarium. Freshly collected leaves were washed with tap water for the removal of earthy matter wiped out the excess water with a muslin cloth and followed by shade drying. Then the shade-dried leaves were coarsely powdered using a Wiley mill. The powdered material was extracted with methanol using a soxhlet extractor to get a crude methanolic extract. The liquid fractions were filtered using a vacuum pump using Whatman filter paper no. 1 and then the filtrate collected was evaporated under reduced pressure using a rotary evaporator (Buchi R-210) at a temperature of 450c until a soft mass was obtained which is collected in a china dish and placed on a water bath for the removal of excess of solvent. The extract which is completely free from solvent was weighed and stored in a desiccator and used for further investigation.
Evaluation of antibacterial activity
Determination of zone of inhibition by cup plate method
The cylinder plate assay of drug potency is based on the measurement of the diameter of the zone of inhibition of microbial growth surrounding cylinders (cups), containing various dilutions of test compounds. A sterile borer was used to prepare cups in the agar medium spread with the micro-organism. Accurately measured (0.05 ml) solution of each concentration and reference standards were added to the cups with a micropipette. All the plates were kept in a refrigerator at 2 to 8 °C for 2 h for effective diffusion of test compounds and standards. Later, they were incubated at 37 °C for 24 h. The presence of a definite zone of inhibition of any size around the cup indicated antibacterial activity. The solvent control was run simultaneously to assess the activity of dimethyl sulphoxide and water which were used as a vehicle. The experiments were performed three times. The diameter of the zone of inhibition was measured and recorded [10].
Column chromatography (CC)
Chromatography is a laboratory technique for the separation of a mixture. The mixture is dissolved in a fluid called the mobile phase, which carries it through the stationary phase. The various constituents of the mixture travel at different speeds according to their RF values, causing them to separate [11-13]. Open column chromatography plays an important role in the separation of compounds from natural product extracts. The separation takes place through the selective distribution of the components between a mobile phase and a stationary phase.
Thin-layer chromatography (TLC)
Thin Layer Chromatography is a very effective technique for the separation of phytoconstituents of an extract and their identification. The history of TLC has been reviewed by various authors [14, 15]. A breakthrough in this field was the commercial availability of convenient precoated plates in the early’70s. Pharmacopeia is increasingly employing this technique for assessing the quality and purity of compounds of both synthetic and natural origin. TLC profiles developed for an extract from a definite solvent system and other parameters could be used as a fingerprint in comparative qualitative evaluation of herbal drugs. The trend of evaluation by this method is becoming popular because of its simplicity and reproducibility. In this technique, the different components are separated by the differential migration of solute between two phases–a stationary phase and a mobile phase. Here, the principle of separation is adsorption and the stationary phase acts as an adsorbent. Depending on the particular type of stationary phase, its preparation, and use with different solvents, separation can be achieved based on the partition or a combination of partition and adsorption.
The selection of the solvent system was based on an increase in the order of polarity. Based on the chemical tests and the nature of phytoconstituents present, the solvent systems were selected. The different spots developed in each system were detected using RF-specific reagents and an iodine chamber.
Isolation of compounds using column chromatography
Preparation of column: A cotton plug was placed at the bottom of the pre-cleaned and dried column. Low polar solvent hexane was poured slowly and then the silica gel (ACME, 60-120 Mesh) was activated at 1050c added by continuous stirring to the solvent hexane in the column, and allowed to set up (Dry Packing).
Preparation of the sample: The concentrated methanolic extract of 50 g was mixed with a sufficient amount of silica gel (ACME, 60-120 Mesh) of column chromatography grade and dried in air. It was then introduced at the top of the silica gel column and the sample bed was covered with a cotton plug it was placed on it gently to avoid air bubbles.
Gradient elution technique: To isolate compounds in a pure state based upon the solubility, the gradient elution technique was used. Initially, the column was eluted with low polar solvent hexane, and the polarity was increased using ethyl acetate methanol (hexane: ethyl acetate, ethyl acetate: methanol, pure methanol). Each fraction containing a volume of 250 ml was collected; the solvent was recovered by distillation. The fractions obtained were monitored by TLC trying with different solvent systems depending upon the eluent used. The TLC spots were visualized using various visualizing agents like 5% H2SO4, UV chamber, and iodine chamber. The collected fractions were concentrated and kept for crystallization. The course of the chromatogram is given in the following table [16].
Structure elucidation of the compound GT-01 revealed the IR spectral data as broadband at 3435.45 cm-1 and other absorption bands at1636.71, C=C stretching frequency. The 1H NMR spectrum showed a doublet at for anomeric proton signal, which confirmed β-anomeric configuration. The 13C NMR indicated the presence of 35 carbon resonances. Out of which six-carbon signals for the steroidal nucleus of the aglycone moiety including the anomeric carbon peak and olefinic carbons six-carbon peaks are similar with those of β-sitosterol β-D-glucoside, which indicates the presence of β-D-glucoside or Daucosterol comparing with the reported 13C NMR data of β-sitosterol [17-21].

The compound was obtained as white power, mp 210oC, and analyzed ESI-MS: Mol. For: C30H50O, found m/z 427.90 [(M-H+), 100.00%], calcd. 426.73. The absorptions under UV were found to be λmax 350 nm and the RF value was found to be 0.64. The IR spectrum has shown broadband at 1023.35, 1456.68, 1646.32, 2928.97, 3426.57, 3747.67, cm-1. The 13C NMR spectral data revealed the presence of 30 carbons where seven methyl, ten methylene, six methine carbons, five quarternary carbons, and two olefinic carbons. The olefinic methylene protons on 29th carbon are seen as singlets at 4.54 (1H, s, =CH-29b) ppm, 4.79 (1H, s, =CH-29a) ppm. The 13C NMR data were in complete agreement with the existence of an isopropenyl group and a vinylic carbon atom. This supports the olefinic methylene protons seen as singlets at 4.54 and 4.79 ppm in the 1H NMR spectrum was found to be consistent with the known compound lupeol. Synonym of Lupeol, Fagarasterol, Clerodol, MonogynolB, Fragnasterol.

The compound was obtained as white crystals. It showed a positive Liebermann-Burchard test for steroids and/or triterpenes. Melting Point 2630C, UV λmax 267 nm, RF value 0.56 were obtained. The mass spectrum of the compound showed a molecular ion [M-H+] at m/z 427.30, which corresponds to the molecular formula C30H50O. The IR spectrum showed a band at 596.02, 660.91, 727.63, 756.03, 798.43, 861.89, 894.62, 953.06, 1018.59, 1039.09, 1138.46, 1203.15, 1241.04, 1283.58, 1311.71, 1353.07, 1425.20, 1458.95, 1610.97, 1644.68, 1667.87, 2588.20, 2874.03, 2956.55, 3440.69 cm-1. Synonym(s) of friedelin were Friedelin; Friedeline; 559-74-0; D: A-Friedooleanan-3-one; Friedelan-3-one

Among natural products, triterpenoids have been considered a promising class for cancer chemoprevention and chemotherapy [22-24] and they have been highlighted as antineoplastic agents [25, 26]. Previous studies reported Lupeol a pentacyclic triterpene, occurs in many medicinal plants, such as in leaves of Maytenus salicifolia Reissek (Celastraceae) [27]. This compound has displayed anti-inflammatory property protective effect during low-density lipoprotein (LDL) oxidation [28, 29] and anticancer activity against different cell lines [melanoma (G361, 451Lu, and WM35), T-lymphoblastic leukemia (CEM), breast carcinoma (MCF-7 and MDA-MB-231), lung carcinoma (A-549), multiple myeloma (RPMI 8226) and cervical carcinoma (HeLa) [30, 31]. Polyphenolic compounds, like flavonoids, tannins, saponins, and phenolic acids, commonly found in plants, have been reported to possess multiple biological effects. The methanolic extract showed good antibacterial activity against Gram-positive bacteria Staphylococcus aureus. The phytoconstituents such as daucosterol, lupeol, and friedelin and many mixtures of compounds were isolated from the leaf extract of Grewia tiliaefolia Vahl [32]. Hence this plant extract can be used for further isolation of compounds and the isolated compounds can be used for curing many ailments.
Table 1: Column chromatography of crude methanolic extract of Grewia tiliaefolia Vahl
| Fraction no | Eluant composition | Compound isolated |
| 1-8 | Pure hexane (100%) | GT-1 |
| 9-20 | Pure hexane (100%) | GT-2 |
| 21-35 | Pure hexane (100%) | Orange color waxes |
| 36-40 | 1 % Ethyl acetate in hexane | GT-3 |
| 41-46 | 2 % Ethyl acetate in hexane | Orange color matter |
| 47-50 | 5% Ethyl acetate in hexane | Orange color waxes |
| 51-60 | 10% Ethyl acetate in hexane | Mixture |
| 61-66 | 20% Ethyl acetate in hexane | Mixture |
| 67-70 | 30% Ethyl acetate in hexane | Orange color waxes |
| 71-75 | 40% Ethyl acetate in hexane | yellow color waxes |
| 76-79 | 50% Ethyl acetate in hexane | yellow color waxes |
| 80-90 | 60% Ethyl acetate in hexane | Reddish yellow color waxes |
| 91-99 | 70% Ethyl acetate in hexane | Reddish-brown matter |
| 100-109 | 80% Ethyl acetate in hexane | Reddish-brown matter |
| 110-119 | 90% Ethyl acetate in hexane | Reddish-brown matter |
| 120-128 | 100% Ethyl acetate | Mixture |
| 129-132 | 2% Methanol in ethyl acetate | Mixture |
| 133-133 | 5% Methanol in ethyl acetate | Mixture |
| 134-140 | 10% Methanol in ethyl acetate | Mixture |
| 141-148 | 20% Methanol in ethyl acetate | Mixture |
| 149-155 | 30% Methanol in ethyl acetate | Mixture |
| 156-160 | 40% Methanol in ethyl acetate | Intangible mass |
| 161-166 | 50% Methanol in ethyl acetate | Intangible mass |
| 167-175 | 60% Methanol in ethyl acetate | Green residue |
| 176-180 | 70% Methanol in ethyl acetate | Intangible mass |
| 181-190 | 80% Methanol in ethyl acetate | Green residue |
| 191-198 | 90% Methanol in ethyl acetate | Green residue |
| 199-210 | 100% Methanol | Sticky matter |
Table 2: 1H NMR (CDCl3, 400 MHz) δ ppm of daucostertol, Lupeol, Friedelin
| Carbon number | 1H NMR (CDCl3, 400 MHz) δ ppm, daucostertol |
1H NMR (CDCl3, 400 MHz) δ ppm, Lupeol |
1H NMR (CDCl3, 400 MHz) δ ppm, frideline |
| 1 | 1.23 (1H, s, CH-1a) 1.48 (1H, s, CH-1b) |
1.37 (1H, m, CH-1a) 1.62 (1H, m, CH-1b) |
1.84 (1H, m, CH-1a) 2.01 (1H, m, CH-1b) |
| 2 | 1.42 (1H, s, CH-2a) 1.73 (1H, s, CH-2b) |
1.58 (1H, s, CH-2a) 1.93 (1H, s, CH-2b) |
2.15 (2H, m, CH-2) |
| 3 | 3.79-3.83 (1H, m, CH-3) | 1.46 (1H, s, CH-3) 3.47 (1H, t, OH-3) |
--- |
| 4 | 2.24-2.28 (1H, m, CH-4a), 1.85 (1H, s, CH-4b) | --- | 2.12 (1H, m, CH-4) |
| 5 | --- | 1.96 (1H, s, CH-5) | --- |
| 6 | 5.46-5.48 (1H, t, J = 4.8 Hz, OH-6) | 1.27 (1H, s, CH-6a), 1.67 (1H, s, CH-6b) | 1.37 (1H, m, CH-6a) 1.62 (1H, m, CH-6b) |
| 7 | 2.00-2.04 (1H, m, CH-7a), 1.77 (1H, s, CH-7b) | 1.37 (1H, m, CH-7a), 1.62 (1H, m, CH-7b) | 1.62 (1H, m, CH-7a) 1.42 (1H, s, CH-7b) |
| 8 | 1.41 (1H, s, CH-8) | --- | 0.91 (1H, s, CH-8) |
| 9 | 2.17-2.19 (1H, m, CH-9) | 1.14 (1H, d, J = 0.8 Hz, CH-9) | --- |
| 10 | --- | --- | 0.94 (1H, s, CH-10) |
| 11 | 1.37 (1H, s, CH-11a) 1.82 (1H, s, CH-11b) |
1.49 (1H, s, CH-11a) 1.14 (1H, d, J = 0.8 Hz, CH-11b) |
1.68 (1H, m, CH-11a) 0.98 (1H, s, CH-11b) |
| 12 | 1.17 (1H, s, CH-12a) 1.37 (1H, s, CH-12b) |
1.47 (1H, s, CH-12a) 0.86 (1H, s, CH-12b) |
1.77 (1H, m, CH-12a) 1.00 (1H, s, CH-12b) |
| 13 | --- | 1.04 (1H, s, CH-13) | --- |
| 14 | 0.97 (1H, s, CH-14) | --- | --- |
| 15 | 1.86 (1H, s, CH-15a) 1.61 (1H, s, CH-15b) |
1.37 (1H, m, CH-15a) 1.62 (1H, m, CH-15b) |
1.62 (1H, m, CH-15a) 1.37 (1H, m, CH-15b) |
| 16 | 1.33 (1H, s, CH-16a) 1.58 (1H, s, CH-16b) |
1.17 (1H, s, CH-16a) 1.37 (1H, m, CH-16b) |
1.62 (1H, m, CH-16a) 1.37 (1H, m, CH-16b) |
| 17 | 1.11 (1H, s, CH-17) | --- | --- |
| 18 | 1.13 (3H, s, CH3-18) | 1.07 (1H, s, CH-18) | 1.75 (1H, m, CH-18) |
| 19 | 1.01 (3H, t, J = 0.8 Hz, CH3-19) | 2.09 (1H, m, CH-19) | 1.03 (1H, s, CH-19a) 1.22 (1H, s, CH-19b) |
| 20 | 1.39 (1H, s, CH-20) | 1.64 (1H, s, CH-20a), 1.39 (1H, s, CH-20b) | --- |
| 21 | 1.18 (1H, s, CH-21a) 1.38 (1H, s, CH-21b) |
1.70 (1H, s, CH-21a) 1.45 (1H, s, CH-21b) |
1.62 (1H, m, CH-21a) 1.37 (1H, m, CH-21b) |
| 22 | 1.29 (1H, s, CH-22a) 1.33 (1H, s, CH-22b) |
1.01 (3H, s, CH3-22) | 1.62 (1H, m, CH-22a) 1.37 (1H, m, CH-22b) |
| 23 | 1.10 (1H, s, CH-23) | 1.01 (3H, s, CH3-23) | 1.23 (3H, s, CH3-23) |
| 24 | 1.24 (1H, s, CH-24a) 1.35 (1H, s, CH-24b) |
1.00 (3H, s, CH3-24) | 1.01 (3H, s, CH3-24) |
| 25 | 1.00 (3H, s, CH3-25) | 1.01 (3H, s, CH3-25) | 1.02 (3H, s, CH3-25) |
| 26 | 1.03 (3H, t, J = 0.8 Hz, CH3-26) | 1.00 (3H, s, CH3-26) | 1.02 (3H, s, CH3-26) |
| 27 | 1.49 (1H, s, CH-27) | 0.98 (3H, s, CH3-27) | 1.02 (3H, s, CH3-27) |
| 28 | 1.03 (3H, t, J = 0.8 Hz, CH3-28) | --- | 1.01 (3H, s, CH3-28) |
| 29 | 1.03 (3H, t, J = 0.8 Hz, CH3-29) | 4.79 (1H, s, =CH-29a), 4.54 (1H, s, =CH-29b) | 1.00 (3H, s, CH3-29) |
| 30 | 5.40 (1H, d, J = 1.2 Hz, OH-30) | 1.78 (3H, s, CH3-30) | 1.00 (3H, s, CH3-30) |
| 31 | 3.40 (1H, s, CH-31) | --- | --- |
| 32 | 1.46 (1H, s, CH-32) 3.45 (1H, dd, J = 0.4, 0.8 Hz, OH-32) |
--- | --- |
| 33 | 3.69-3.70 (1H, dd, J = 1.2, 1.6 Hz, OH-33) 0.83 (1H, s, CH-33) |
--- | --- |
| 34 | 3.62-3.64 (1H, s, dd, J = 1.2, 1.6 Hz,OH-34) 1.15 (1H, s, CH-34) |
--- | --- |
| 35 | 3.47 (1H, d, J = 1.6 Hz, H-35a) 1.08 (1H, s, CH-35b) 3.72 (1H, d, J = 0.8 Hz, OH-35) |
--- | --- |
Table 3: 13C NMR (CDCl3, 400 MHz) δ ppm, Daucostertol, Lupeol, Friedelin
| Carbon number | 13C NMR (CDCl3, 400 MHz)δ ppm, daucostertol | 13C NMR (CDCl3, 400 MHz), δ ppm | 13C NMR (CDCl3, 400 MHz)δ ppm |
| 1 | 36.95 | 37.97 (C-1) | 22.76 |
| 2 | 29.65 | 27.72 (C-2) | 40.37 |
| 3 | 78.16 | 75.51 (C-3) | 212.18 |
| 4 | 39.10 | 39.59 (C-4) | 57.39 |
| 5 | 141.21 | 54.89 (C-5) | 40.96 |
| 6 | 122.08 | 18.87 (C-6) | 40.22 |
| 7 | 31.88 | 35.48 (C-7) | 19.34 |
| 8 | 35.12 | 41.12 (C-8) | 50.83 |
| 9 | 50.51 | 51.06 (C-9) | 37.70 |
| 10 | 38.15 | 37.70 (C-10) | 57.70 |
| 11 | 22.38 | 21.33 (C-11) | 36.56 |
| 12 | 39.10 | 26.55 (C-12) | 30.00 |
| 13 | 43.44 | 37.97 (C-13) | 40.00 |
| 14 | 58.13 | 41.98 (C-14) | 41.70 |
| 15 | 24.86 | 28.96 (C-15) | 30.45 |
| 16 | 28.15 | 35.68 (C-16) | 35.93 |
| 17 | 56.86 | 42.94 (C-17) | 31.18 |
| 18 | 19.64 | 49.26 (C-18) | 43.59 |
| 19 | 13.94 | 48.17 (C-19) | 37.21 |
| 20 | 36.29 | 30.10 (C-20) | 30.13 |
| 21 | 35.41 | 39.08 (C-21) | 35.34 |
| 22 | 28.30 | 23.78 (C-22) | 38.85 |
| 23 | 45.01 | 23.78 (C-23) | 9.57 |
| 24 | 24.95 | 17.47 (C-24) | 15.78 |
| 25 | 12.11 | 16.08 (C-25) | 16.08 |
| 26 | 18.77 | 17.47 (C-26) | 17.47 |
| 27 | 31.13 | 23.21 (C-27) | 17.47 |
| 28 | 19.87 | 151.14 (C-28) | 25.29 |
| 29 | 19.87 | 109.99 (C-29) | 28.60 |
| 30 | 101.49 | 21.48 (C-30) | 28.60 |
| 31 | 76.65 | --- | --- |
| 32 | 70.46 | --- | --- |
| 33 | 74.80 | --- | --- |
| 34 | 73.84 | --- | --- |
| 35 | 62.26 | --- | --- |

Fig. 1: FT-IR spectrum of the compound GT-01, Daucosterol

Fig. 2: 1H Spectrum of the compound GT-01, Daucosterol

Fig. 3: 13CNMR spectrum of the compound GT-01, daucosterol

Fig. 4: Mass spectrum of the compound GT-01, daucoste

Fig. 5: FR-IR spectrum of the compound GT-02, Lupeol

Fig. 6: 1H NMR spectrum of the compound GT-02, Lupeol

Fig. 7: 13 CNMR spectrum of the compound GT-02, Lupeol

Fig. 8: Mass spectrum of the compound GT-02, Lupeol

Fig. 9: FT-IR spectrum of the compound GT-03, Friedelin

Fig. 10: 1H NMR spectrum of the compound GT-03, Friedelin

Fig. 11: 13CNMR spectrum of the compound GT-03, Fredelin

Fig. 12: Mass spectrum of the compound GT-03, friedelin
The antibacterial activity of the crude methanolic extract of Grewia tiliaefolia Vahl against Gram-positive (Bacillus subtitles, Staphylococcus aureus), and Gram-negative (Escherichia coli, Pseudomonas aeruginosa) was carried out. Moorthy et al. reported that the Wrightia tinctoria (Roxb.) R. Br zone diameter obtained with petroleum ether extracts showed 25.0±1.01 mm, and for the methanolic extract of it was 27.2±0.91 mm [33]. A higher zone of inhibition was observed in Staphylococcus aureus with a zone diameter of 34.1±0.513 mm at a concentration of 10 mg/ml. The standard amikacin showed 35 mm at a concentration of 2 mg/ml shown in [table 4 and fig. 13].
Table 4: Antibacterial activity of methanolic leaf extract of Grewia tiliaefolia vahl
| Treatments | Concentration (mg/ml) |
Zone of growth inhibition (mm) | |||
| gram (+) ve | Gram (-)ve | ||||
| B. s | S. a | E. c | P. a | ||
| Methanolic extract | 2 4 6 8 10 |
15.1±0.9 16±0.8 17.2±1.2 18.03±1.2 19.3±0.7 |
28.1±1.0 29.1±0.54 32.1±0.88 33.1±0.9 34.1±0.513 |
10.8±0.8 12.6±0.6 13.4±1.2 14.5±1.3 15.3±1.0 |
20±1.2 21.2±0.84 22.3±0.4 23.4±0.8 24.6±0.9 |
| Amikacin | 2 | 30.5±0.9 | 35±0.25 | 34±0.51 | 35.2±0.8 |
Mean±SD, where n=3, S. a=Staphylococcus aureaus; E. c=E-scherichia coli; P. a=Pseudomonas aeruginosa, B. s= bacillus substilis.
Fig. 13: Growth inhibition of methanolic extract against Staphylococcus aureus
Extraction of crude methanolic extract was done successfully and three compounds were isolated from methanolic extract of the leaf using column chromatography, namely daucosterol, lupeol, and friedelin. characterization of isolated compounds was done by using UV, FTIR, NMR, MASS spectroscopic techniques, and antimicrobial activity was carried out on the crude methanolic extract Gram-positive (Bacillus subtitles, Staphylococcus aureus), and Gram-negative (Escherichia coli, Pseudomonas aeruginosa) was carried out. Against Staphylococcus aureus with a zone diameter of 34 mm at a concentration of 10 mg/ml was observed. Hence Grewia tiliaefolia Vahl methanolic extract has potent phytoconstituents and acts as a selectively potent antibacterial agent.
Authors are thankful to University Grants Commission for providing financial support and Andhra University for providing the necessary laboratory facilities.
1. Have made significant commitments to conception and plan, or procurement of information, or examination and translation of information.
2. Have given the last endorsement of the form to be published
3. Have aided in the antimicrobial work
4. Have been engaged with drafting the composition or modifying it basically for significant scholarly substance
All authors declare no conflict of interest.
Cos P, Vlietinck AJ, Berghe DV, Maes L. Anti-infective potential of natural products: how to develop a stronger in vitro ’proof-of-concept’. J Ethnopharmacol. 2006 Jul 19;106(3):290-302. doi: 10.1016/j.jep.2006.04.003. PMID 16698208.
Lavekar GS, Padhi MM, Mangal AK, Joseph GVR, Raman KG, Selvarajan S, Dennis TJ. Database on medicinal plants used in Ayurveda and Siddha. New Delhi: Central Council for research in Ayurveda and Sidha; 2008.
Mishra RK, Patel SP, Srivastava A, Vashistha RK, Singh A, Puskar AK. Ethnomedicinally important plants of pachmarhi region, Madhya Pradesh, India. Nat Sci. 2012;10:22-6.
Zia-Ul-Haq M, Stankovic MS, Rizwan K, Feo VD. Grewia asiatica L., a food plant with multiple uses. Molecules. 2013 Feb 28;18(3):2663-82. doi: 10.3390/molecules18032663, PMID 23449066, PMCID PMC6270019.
Devi DR, Battu GR. Qualitative phytochemical screening and FTIR spectroscopic analysis of grewia tilifolia (Vahl) leaf extracts. Int J Curr Pharm Sci. 2019 Jul 15-11;4:100-7, doi: 10.22159/ijcpr.2019v11i4.34936.
Burnett J, Newman B, Sun D. Targeting cancer stem cells with natural products. Curr Drug Targets. 2012 Jul;13(8):1054-64. doi: 10.2174/138945012802009062, PMID 22594473.
Christen P, Cuendet M. Plants as a source of therapeutic and health products. Chimia (Aarau). 2012;66(5):320-3. doi: 10.2533/chimia.2012.320, PMID 22867544.
Hung HY, Qian K, Morris Natschke SL, Hsu CS, Lee KH. Recent discovery of plant-derived anti-diabetic natural products. Nat Prod Rep. 2012 May 1;29(5):580-606. doi: 10.1039/c2np00074a, PMID 22491825.
Newman DJ, Cragg GM. Natural products as sources of new drugs over the last 25 years J Nat Prod. 2007 Mar;70(3):461-77. doi: 10.1021/np068054v. PMID 17309302.
Pharmacopoeia I. Ministry of Health and Family Welfare, Govt. of India. Controller of publications, New Delhi. 1996;736:A80-83.
Kokate CK. Practical pharmacognosy. 3rd ed. New Delhi. VPBN; 1991;3:107-11.
Paech K, Tracey MV. Modern methods of plant analysis/moderne methoden der pflanzenanalyse. Vol. 2. Springer Science+Business Media; 2013 Nov 11.
Shas BS, Quadry JS. Textbook of pharmacognosy. 3rdEdn. BS. India: Prakasham Publishers; 1980. p. 16, 24.
Heftman E. History of chromatography. In: chromatography-a laboratory New York; 1975. p. 1-13.
Kirchner JG. Modern techniques in TLC. Journal of Chromatographic Science. 1975;13(12):558-63. doi: 10.1093/chromsci/13.12.558.
Przybylowicz EP, Staudenmayer WJ, Perry ES, Baitsholts AD, Tischer TN. Precoated sheets for thin-layer chromatography. J Chromatogr. 1965 Dec;20(3):506-13. doi: 10.1016/s0021-9673(01)97452-7, PMID 5881186.
Harun-Or-R M, NK, MAG, MGS, ASMA, NS, ATMZA. Isolation and biological activities of chemical constituents from the stems of Ipomoea turpethum. Pak J Biol Sci. 2006;9(12):2261-6. doi: 10.3923/pjbs.2006.2261.2266.
You YJ, Nam NH, Kim Y, Bae KH, Ahn BZ. Antiangiogenic activity of lupeol from Bombax ceiba. Phytother Res. 2003 Apr;17(4):341-4. doi: 10.1002/ptr.1140, PMID 12722136.
Eldohaji LM, Fayed B, Hamoda AM, Ershaid M, Abdin S, Alhamidi TB, Mohammad MG, Omar HA, Soliman SSM. Potential targeting of Hep3B liver cancer cells by lupeol isolated from avicennia marina. Arch Pharm (Weinheim). 2021 Sep;354(9):e2100120. doi: 10.1002/ardp.202100120. PMID 34085721.
Chatterjee I, Chakravarty AK, Gomes A. Daboia russellii and Naja kaouthia venom neutralization by lupeol acetate isolated from the root extract of Indian sarsaparilla Hemidesmus indicus R.Br. J Ethnopharmacol. 2006;106(1):38-43. doi: 10.1016/j.jep.2005.11.031. PMID 16426782.
Bulus A, Ben AC, Florence DT, Oluwakanyinsola AS, Ogbaji JI. Isolation and analgesic property of lupeol from diospyros mespiliformis stem bark. J Med Plants Res. 2015 Aug 10;9(30):813-9, doi: 10.5897/JMPR2015.5877.
Saleem AIH, Alsaedi A, Alharbi M, Abdullah S, Al Rabou A, AlDabbagh M. Mucormycosis in pediatric oncology patients: a hospital outbreak investigation report. Infect Prev Pract. 2021;3(4):100189. doi: 10.1016/j.infpip.2021.100189, PMID 34988423
Hafeez B, Asim M, Suh Y, Yun JM, Setaluri V, Mukhtar H. Lupeol inhibits growth of highly aggressive human metastatic melanoma cells in vitro and in vivo by inducing apoptosis. Clin Cancer Res. 2008 Apr 1;14(7):2119-27. DOI: 10.1158/1078-0432. CCR-07-4413. PMID: 18381953.
Lachance H, Wetzel S, Kumar K, Waldmann H. Charting, navigating, and populating natural product chemical space for drug discovery. J Med Chem. 2012 Jul 12;55(13):5989-6001. doi: 10.1021/jm300288g. PMID 22537178.
Gali Muhtasib H, Hmadi R, Kareh M, Tohme R, Darwiche N. Cell death mechanisms of plant-derived anticancer drugs: beyond apoptosis. Apoptosis. 2015 Dec;20(12):1531-62. doi: 10.1007/s10495-015-1169-2, PMID 26362468.
Laszczyk MN. Pentacyclic triterpenes of the lupane, oleanane and ursane group as tools in cancer therapy. Planta Med. 2009 Dec;75(15):1549-60. doi: 10.1055/s-0029-1186102, PMID 19742422.
Siddique HR, Saleem M. Beneficial health effects of lupeol triterpene: a review of preclinical studies. Life Sci. 2011 Feb 14;88(7-8):285-93. doi: 10.1016/j.lfs.2010.11.020. PMID 21118697.
Nunez MJ, Reyes CP, Jimenez IA, Moujir L, Bazzocchi IL. Lupane triterpenoids from Maytenus species. J Nat Prod. 2005 Jul;68(7):1018-21. doi: 10.1021/np058016w, PMID 16038541.
Saleem M. Lupeol, a novel anti-inflammatory and anti-cancer dietary triterpene. Cancer Lett. 2009 Nov 28;285(2):109-15. doi: 10.1016/j.canlet.2009.04.033. PMID 19464787, PMCID PMC2764818.
Salminen A, Lehtonen M, Suuronen T, Kaarniranta K, Huuskonen J. Terpenoids: natural inhibitors of NF-kappaB signaling with anti-inflammatory and anticancer potential. Cell Mol Life Sci. 2008 Oct;65(19):2979-99. doi: 10.1007/s00018-008-8103-5, PMID 18516495.
Geetha T, Varalakshmi P, Latha RM. Effect of triterpenes from Crataeva nurvala stem bark on lipid peroxidation in adjuvant induced arthritis in rats. Pharmacol Res. 1998 Mar;37(3):191-5. doi: 10.1006/phrs.1997.0278, PMID 9602466.
Andrikopoulos NK, Kaliora AC, Assimopoulou AN, Papapeorgiou VP. Biological activity of some naturally occurring resins, gums and pigments against in vitro LDL oxidation. Phytother Res. 2003 May;17(5):501-7. doi: 10.1002/ptr.1185, PMID 12748987.
Bhattacharya S. Are we in the polyphenols era? Pharmacogn Res. 2011 Apr;3(2):147. doi: 10.4103/0974-8490.81966, PMID 21772762, PMCID PMC3129027.
Moorthy K, Aravind A, Punitha T, Vinodhini R, Suresh M, Thajuddin N. In vitro Screening of antimicrobial activity of wrightia tinctoria (Roxb.) R.Br. Asian. Pharm Clin Res. 2012;201(5):4.